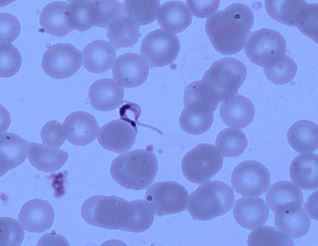

Describe the lifecycle of the malaria parasite, Plasmodium sp.
sporozoite: hepatocyes - schizogony
merozoites: erythrocytes - more schizogony and dif into gametocytes
zygote: in gut membrane - divide to produce large numbers of sporozoites
sporozoites: travel to mosquito salive, inject into humans, process repeats

Entamoeba histolytica

Naegleria fowleri

Balantidium coli

Giardia lamblia

Leishmania tropica
Trypanosoma cruzi

Toxoplasma gondii
Name the vector/transmission, disease, and symptoms
Entamoeba histolytica
fecal-oral route; amoebic dysentary (amebiasis); dysentary
Name the vector/transmission, disease, and symptoms
Naegleria fowleri
contaminated water entering nasal passages; PAM (primary ameobic meningoenchephalitis); fever, headache neurological symptoms, death < 2 weeks
Name the vector/transmission, disease, and symptoms
Balantidium coli
fecal-oral route; Balantidiasis; dysentery
Name the vector/transmission, disease, and symptoms
Giardia lamblia
fecal-oral route; Giardiasis; dysentary
Name the vector/transmission, disease, and symptoms
Leishmania tropica
direct contact/sand flies; Cutaneus leishmariasis; leisions
Name the vector/transmission, disease, and symptoms
Trypanosoma cruzi
kissing bugs; schagas disease/american tryponsumiasis; fever, edema, heart failure (long term)
Name the vector/transmission, disease, and symptoms
Toxoplasma gondii
cat feces; toxoplasmosis; fatigue, muscle aches, still birth, liver/brain damage in fetus
What do protozoan cysts, fungal spores, bacterial endospores, and bacterial exospores have in common?
they are all a means of environmental resistance for survival
what purpose does a protozoan cyst serve
non-reproductive, short-term means of surviving between hosts
what purpose does a fungal spore serve
reproductive, resting state, can generate into another individual of the species
what purpose do bacterial endospores serve
non-reproductive. forms new internal daughter cell, long term means of surviving harsh conditions
what purpose do bacterial exospores serve
reproductive, less resistant than exospores


